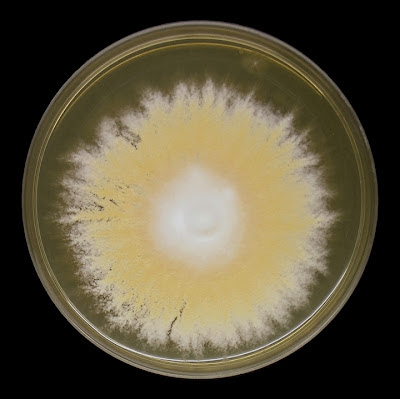

Microsporum gypseum(Fungus/dermatophyte)
Ecology & Pathology:Micrsporum gypseum is a geophilic (soil loving) dermatophyte which occasionally causes skin infections (tinea corporis) and/or scalp infections (tinea capitis). Onychomycosis (nail infections) have also been reported. It has also been isolated from horses, dogs, cats and rodents. A cosmopolitan fungus (found worldwide).
Macroscopic Morphology: As with other fungi, colour is influenced by the media it is grown on. Colony generally described as yellowish-buff to a dark cream or tan colour in colour. The colony may develop a sterile white ‘feathered’ hyphal border or a cottony white raised center. The reverse may be yellow, orange-tan or brownish-red in colour with possible pink to purplish tinges. Colonies are generally flat with a granular or powdery texture and exhibit a moderately rapid growth rate, maturing in about one week.
Microsporum gypseum SAB at 7 Days (Nikon)
Microscopic Morphology: M.gypseum has septate hyphae along which sessile or stalked clavate (club shaped) microconidia (3 – 8 µm X 2 -3 µm) may be found. The fusiform (spindle shaped) macroconidia (8 – 15 µm X 22 – 60 µm) are relatively thin walled, verrucose (with bumpy surface) and contain about 3 – 6 internal cells. M. gypseum’s macroconidia has a rounded apical end while the base is truncated and may show an annular frill. They are usually produced in great numbers. This differentiates M.gypseum’s macroconidia from the M.canis macroconidia which has rather pointed ends and the rather rare & distorted macroconidia produced byM.audounii.Note: Photos that follow were taken with the Leica DMD-108 digital microscope.
M.gypseum -Slide culture at 48 hours (X100 LPCB)
M.gypseum -Slide culture (X250 LPCB)
Hyphae throughout, some showing microconidia, larger macroconidia at left of photo
M.gypseum -microconidia along hyphae are more visible in this photo. Several macroconida throughout. (X250 LPCB)
M.gypseum - another view of both macro & micro conidia (X250 LPCB)
M.gypseum macroconidia (X 400 LPCB)
(Note 100 µm bar at top right of photo)
M.gypseum macroconidia and sessile microconidia attached to hyphae
(X400 LPCB)
M.gypseum clavate microconidia (sessile & stalked?) attached to hyphae
(X1000 LPCB)
M.gypseum - numerous fusiform (spindle) shaped macroconida
(X400 LPCB)
M.gypseum - numerous macroconidia showing up to six internal cells in each. Rough 'verrucose' surface is evident. Adhesive tape preparation. (X1000 LPCB)
M.gypseum macroconidia - on left still attached to conidophore, Rough verrucose surface on lower middle macroconida. (X1000 LPCB)
M.gypseum - more of the same, but I just love them!
(X1000 LPCB)
M.gypsium - macroconidia and a few microconidia (X1000 LPCB)
M.gypseum macroconidium showing rounded apical end and truncated end where once attached to conidiophore. Six internal cells or compartments visible. Rather thin walled with somewhat rough texture evident. (X1000+10 LPCB)
M. gypseum - nearly identical to the macroconidia above, this cell also has six internal cells or compartments with verrucose surface. Nature's own canoe! (X1000+10 LPCB)
* * *
Physiological Tests: M.gypseumis positive for the hair perforation test. It requires no special growth factors and produces no change in pH when inoculated into BCP-milk solids-glucose media. It is urea positive.
M.gypseum - Intended as computer wallpaper (1024 X 768 when posted)